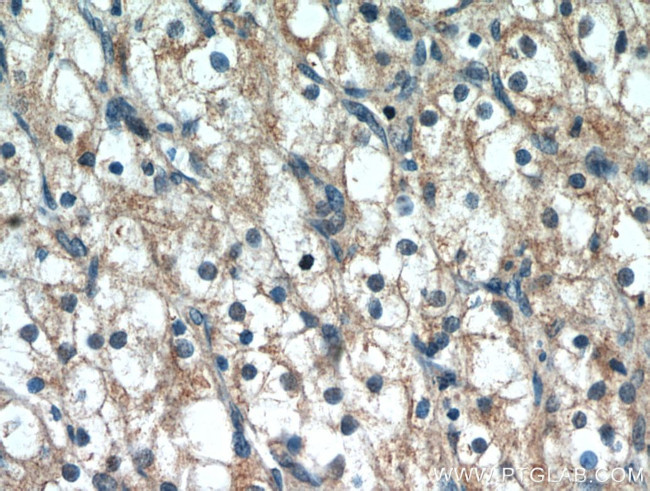
PTH2R Antibody in Immunohistochemistry (Paraffin) (IHC (P))

Search
Proteintech
PTH2R Polyclonal Antibody
{{$productOrderCtrl.translations['antibody.pdp.commerceCard.promotion.promotions']}}
{{$productOrderCtrl.translations['antibody.pdp.commerceCard.promotion.viewpromo']}}
{{$productOrderCtrl.translations['antibody.pdp.commerceCard.promotion.promocode']}}: {{promo.promoCode}} {{promo.promoTitle}} {{promo.promoDescription}}. {{$productOrderCtrl.translations['antibody.pdp.commerceCard.promotion.learnmore']}}
产品信息
14166-1-AP
种属反应
宿主/亚型
分类
类型
抗原
偶联物
形式
浓度
规格
纯化类型
保存液
内含物
保存条件
运输条件
产品详细信息
Immunogen sequence: EVQAEVKKM WSRWNLSVDW KRTPPCGSRR CGSVLTTVTH STSSQSQVAA STRMVLISGK AAKIASRQPD SHITLPGYVW SNSEQDCLPH SFHEETKEDS GRQGDDILME KPSRPMESNP DTEGCQGETE DVL (419-550 aa encoded by BC036811)
靶标信息
PTHR2 is a specific receptor for parathyroid hormone. The activity of this receptor is mediated by g proteins which activate adenylyl cyclase. PTHR2 may be responsible for PTH effects in a number of physiological systems, and may also play a significant role in pancreatic function. PTHR2 presence in neurons indicates that it may function as a neurotransmitter receptor.
仅用于科研。不用于诊断过程。未经明确授权不得转售。
篇参考文献 (0)
生物信息学
蛋白别名: G-protein coupled receptor; Hpth2 receptor; Parathyroid hormone 2 receptor; parathyroid hormone receptor; parathyroid hormone receptor 2; PTH2 receptor; unnamed protein product
基因别名: PTH2R; PTHR2
UniProt ID: (Human) P49190, (Rat) P70555, (Mouse) Q91V95
Entrez Gene ID: (Human) 5746, (Rat) 81753, (Mouse) 213527